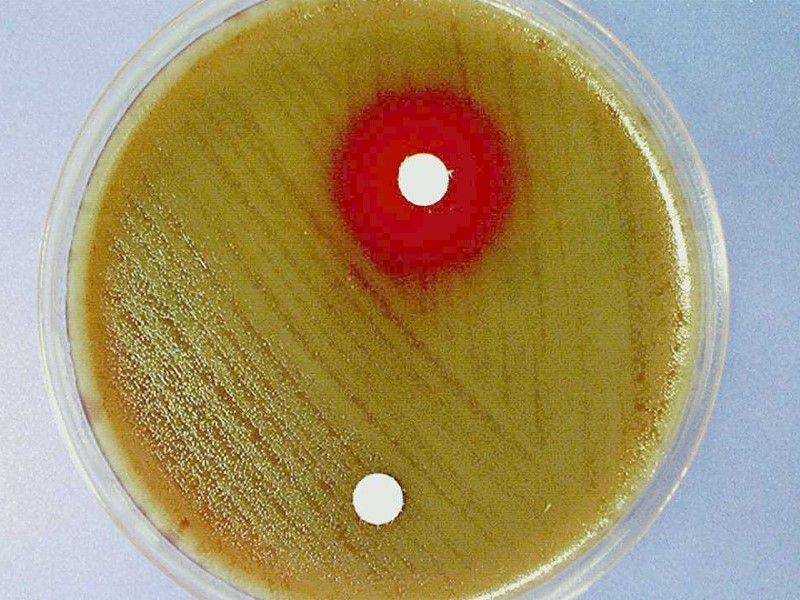

АНТИБИОТИКОТЕРАПИЯ Симонов С.С. Чашка Петри Александра Флеминга Пенициллин


АНТИБИОТИКОТЕРАПИЯ Симонов С.С.

Чашка Петри Александра Флеминга Пенициллин впервые обнаружен в 1928 году британским врачом Александром Флемингом Случайно открыт в загрязненной бактериальной культуре Гриб Penicillium notatum подавлял культуру Staphylococcus aureus, растущую в чашке Петри

Чашка Петри Александра Флеминга

Прокариотическая клетка в сравнении с эукариотической Бактериальная клетка (прокариот) Клетка животного (эукариот) Митохондрия и митохондриальная ДНК Клеточная стенка Мембрана Хромосома (циркулярная; одна копия ДНК - гаплоидная) Хромосома (линейная; две копия ДНК - диплоидная) Мембрана Ядро Плазмида

Мишени для клинически важных антибиотиков Синтез протеинов Аминогликозиды Макролиды Тетрациклины Хлорамфеникол

Механизмы действия антибиотиков (пневмококк)

Two cell types Applied Microbiology

8 - DNA complexed with protein constitutes the genetic material as chromosomes - Bacterial chromosomes are a single circular loop - Eukaryotic chromosomes are multiple and linear

Синтез клеточной стенки Циклосерин Гликопептиды (ванкомицин, teicoplanin) Bacitracin Бета-лактамы (пенициллины, цефалоспорины, карбапенемы, монобактамы)


Бета-лактамное кольцо ПЕНИЦИЛЛИНЫ пенициллин, cloxacillin, flucloxacillin, ампициллин, амоксициллин, carbenicillin, ticarcillin, azlocillin, mezlocillin, piperacillin ЦЕФАЛОСПОРИНЫ cephalexin, цефаклор, cefadrxil, cefuroxime, cefamandole, cefotaxime, ceftazidime, cetriaxone O R S COOH N R

Бета-лактамное кольцо O R N O R C COOH N КАРБАПЕНЕМЫ imipenem OSO3 МОНОБАКТАМЫ aztreonam R

Inhibition of Cell Wall Synthesis Peptidoglycan b-lactam Bulging surface of cocci Weak points in peptidoglycan

Ингибиторы синтеза бактериальной клеточной стенки Клеточная стенка Прикрепление нового элемента пептидогликана UDP L-лизин D-аланин

UDP Гликопептиды связываются с терминальными остатками D-ala-D-ala, предотвращая включение субъединицы в растущий пептидогликан ВОРЧАНИЕ NAM P P C55 липид L-лизин Ингибиторы синтеза бактериальной клеточной стенки

Ингибиторы протеинового синтеза Аминогликозиды Макролиды Тетрациклины Хлорамфеникол Фузидиновая кислота



Инициирование Синтеза Протеинов

Продолжение Синтеза Протеинов

Блокада рибосомы

Targeting Protein Synthesis and Function


Макролиды – присоединение к рибосоме

Макролиды – блокировка туннеля Steitz: Mol. Cell 10, 117 (2002)

Другие антибиотики блокирующие туннель Franceschi: Nature 413, 814 (2001)

Известные мутации «резистентности»

Синтез нуклеиновых кислот: Ингибиция синтеза предшественников СУЛЬФОНИЛАМИДЫ ТРИМЕТОПРИМ Ингибиторы репликации ДНК ХИНОЛОНЫ Ингибиторы РНК полимеразы РИФАМПИЦИН

PABA Дигидрофолиевая кислота Тетрагидрофолиевая кислота Предшественники Пурины ДНК X X SULFA TRIMETHOPRIM

Change in metabolic patterns Produce slightly different enzyme Abandon metabolic pathway Create a new metabolic pathway Sulfonamide & trimethoprim resistance

Антимикробные средства, затрагивающие бактериальную ДНК и РНК Рифампицин - специфичный ингибитор бактериальной ДНКзависимой РНК полимеразы, блокирует иРНК Метронидазол – при восстановлении реагирует с ДНК, окисляя её и вызывая прерывание цепочки

Синтез нуклеиновой кислоты: Ингибиторы репликации ДНК ХИНОЛОНЫ (напр. ципрофлоксацин - фторхинолон) большое семейство синтетических препаратов, которые воздействуют на ДНК гиразу ДНК гираза, необходима для суперспирализации бактериальной ДНК (также важна для репарации ДНК) - бактерии неспособны 'упаковывать' ДНК в клетку

Организация бактериальной хромосомы и мишени действия хинолонов Бактерия 2 – 5 мкм Хромосома 1 500 мкм Суперспирализация ДНК - гираза ? Бинарное деление клетки Репликация хромосомы Топоизомераза IV


Essential Metabolite Selective Toxicity

Окраска по Граму Грамотрицательные Грамположительные Приготовление мазка Окраcка Фиксирование Окраска Обесцвечивание алкоголем

Красный: клеточная мембрана Черный: пептидогликан Зелёный: внешняя мембрана

Some penicillins are less effective against Gram negative bacteria. Some cannot penetrate the outer membrane well. Broad spectrum penicillins and cephalosporins can cross the cell walls of Gram negative bacteria. Carbenicillin & ceftriaxone

Figure 27.5 Gram-positive and gram-negative bacteria

Figure 27.5x Gram-positive and gram-negative bacteria Gram+ Thick peptidoglycan wall holds violet dye Gram- Thin peptidoglycan wall can’t hold violet dye, then stained red

lag log Стационарная фаза

lag log





Бактерицидные Цефалоспорины Аминогликозиды Пенициллины Фторхинолоны Бактериостатики Тетрациклин Эритромицин Хлорамфеникол Линкозамиды



СИНЕРГИЗМ

ИСПОЛЬЗОВАНИЕ БОЛЕЕ ОДНОГО АНТИБИОТИКА Комбинированная терапия уменьшает появление устойчивости Туберкулез ВИЧ

АНТАГОНИЗМ Комбинация Бактериостатического и Бактерицидного Тетрациклин и пенициллин при менингите. Смертность 21 % против 79 %

ЛОКАЛЬНЫЕ ФАКТОРЫ ВЛИЯЮЩИЕ НА АКТИВНОСТЬ АНТИБИОТИКА Абсцесс - гной связывает антибиотик Гематома - эритроцит связывает антибиотики. pH – повышает или уменьшает активность Инородное тело

Бактерицидные Цефалоспорины Аминогликозиды Пенициллины Фторхинолоны Бактериостатики Тетрациклин Эритромицин Хлорамфеникол Линкозамиды

При определении чувствительности диско-диффузионным методом на поверхность агара в чашке Петри наносят бактериальную суспензию определенной плотности и затем помещают диски, содержащие определенное количество антибиотика. Диффузия антибиотика в агар приводит к формированию зоны подавления роста микроорганизмов вокруг дисков. Чувствительность к антибиотику

Чувствительность к антибиотику МБК МБК: Минимальная бактерицидная концентрация – наименьшая концентрация антибиотика которая при исследовании in vitro вызывает гибель 99,9% микроорганизмов от исходного уровня в течение определенного периода времени. МПК МПК: Минимальная подавляющая концентрация – наименьшая концентрация антибиотика, которая in vitro полностью подавляет видимый рост бактерий.

But Remember- must reach that concentration in blood or in specific tissue!!

Определение чувствительности микроорганизма с помощью Е-теста проводится с использованием полоски Е-теста, содержащей градиент концентраций антибиотика от максимальной к минимальной. В месте пересечения эллипсовидной зоны подавления роста с полоской Е-теста получают значение минимальной подавляющей концентрации (МПК). Чувствительность к антибиотику



Смертные случаи в 100 000 Уровни смертности пневмонии в 100 000 пациентов в США от 1900-1990 0 20 40 60 80 100 120 140 160 180 200 1900 1910 1920 1930 1940 1950 1960 1970 1980 1990 Недостаток эффективной терапии; увеличение смертности Внегоспитальная пневмония: Смертность


Потребление макролидов амбулаторными пациентами в Финляндии в 1980 - 1994 гг. (Seppala H. et al., 1997)

Частота выделения эритромицинорезистентных S. pyogenes в Финляндии в 1990 - 1996 гг. (%)

Пенициллин Цефтриаксон/ сульбактам Эритромицин Азитромицин Хлорамфеникол Спирамицин Клиндамицин Кларитромицин Гатифлоксацин Тетрациклин Ванкомицин ЧАСТОТА (%) УМЕРЕННОРЕЗИСТЕНТНЫХ И РЕЗИСТЕНТНЫХ S. pneumoniae (1999-2000 гг.) Число штаммов – 210 (ПеГАС-I, фаза «А») Мидекамицин Козлов Р.С. и соавт. Клин. микроб. антимикроб. химиотер., 2002; 4: 267-77 Умереннорезистентные штаммы Резистентные штаммы Ко-тримоксазол Цефепим Амоксициллин

Пенициллин Амоксициллин Амоксициллин/ клавуланат Эритромицин Азитромицин Хлорамфеникол Спирамицин Клиндамицин Кларитромицин Моксифлоксацин Тетрациклин Ко-тримоксазол Ванкомицин Число штаммов – 581 (ПеГАС-I, фаза «Б») Умереннорезистентные штаммы Резистентные штаммы ЧАСТОТА (%) УМЕРЕННОРЕЗИСТЕНТНЫХ И РЕЗИСТЕНТНЫХ S. pneumoniae (2001-2003 гг.) Цефтриаксон/ сульбактам

Пенициллин Амоксициллин Амоксициллин/ клавуланат Эритромицин Азитромицин Хлорамфеникол Спирамицин / Мидекамицин Клиндамицин Кларитромицин Моксифлоксацин Тетрациклин Ко-троксазолим Ванкомицин Число штаммов – 913 (ПеГАС-II) Умереннорезистентные штаммы Резистентные штаммы ЧАСТОТА (%) УМЕРЕННОРЕЗИСТЕНТНЫХ И РЕЗИСТЕНТНЫХ S. pneumoniae (2003-2005 гг.) Козлов Р.С. и др. Клин. микробиол. антимикроб. химиотер.; 2006; 8(1): 33-47 Цефтриаксон/ сульбактам

Азитромицин 0 / 1,5 Ампициллин Амоксициллин/ клавуланат Цефтриаксон 0 0 0,8 / 4,6 Умереннорезистентные штаммы Резистентные штаммы Число штаммов - 258 ЧАСТОТА (%) УМЕРЕННОРЕЗИСТЕНТНЫХ И РЕЗИСТЕНТНЫХ H. influenzae Kozlov R.S., e.a. Proceedings of the 8 ECCI & 4 ECVD, 2006; 116

Sources: Alexander Project, FINRES, STRAMA, DANMAP, and Cars O, et al. Lancet 2001; 357: 1851-3. Macrolide-Resistant S. pneumoniae (MRSP) and Macrolide Consumption in 14 EU Member States, 1997-1998

Slide no 72 Time Antibacterial concentration (µg/ml) 2 Drug A Drug B Drug A present at concentration of 2 µg/ml for 50% of dosing interval Drug B present at concentration of 2 µg/ml for 30% of dosing interval 4 6 8 0 Time above MIC Correlation of serum pharmacokinetics with MIC (susceptibility) of an organism

1 Antibiotic-sensitive Antibiotic-resistant Dead

Staphylococcus aureus Pseudomonas aeruginosa Enterococcus sp. 52 % 23 % 28 % 10 % Resistance in the Intensive Care Unit National Nosocomial Infections Surveillance System Report, 2003 Klebsiella pneumoniae

In the Community : Macrolide resistance 32 % 20-90 % Streptococcus pneumoniae Helicobacter pylori Streptococcus pyrogenes Haemophilus influenzae Up to 70 % Ineffective

Methicillin against . macrolide resistance Vancomycin used . against MRSA MRSA

Methicillin against . macrolide resistance Vancomycin used . against MRSA Linezolid against VRE MRSA VRE

МЕХАНИЗМЫ УСТОЙЧИВОСТИ К АНТИБИОТИКАМ

Механизмы антимикробной резистентности Инактивация антибиотика Нарушение проницаемости Модификация мишени Активный эффлюкс


Насосы Эффлюкса мембрана клетки бактерий антибиотическая цель

Multidrug resistant pumps Self defense ejection system Lack selectivity & can pump out antimicrobials, detergents and toxins publications.nigms.nih.gov/.../pump_it_up/

Диссеминация генов устойчивости 1. Хромосомная: отбор мутанта 2 Плазмидная: распространение устойчивости Плазмиды - молекулы ДНК которые копируются независимо от бактериальной хромосомы донор реципиент трансконъюгант Антибиотики

Ведущим механизмом устойчивости к фторхинолонам является модификация мишеней - двух бактериальных ферментов ДНК-гиразы и топоизомеразы IV, опосредующих конформационные изменения в молекуле бактериальной ДНК, необходимые для ее нормальной репликации. Каждый из ферментов состоит из четырех субъединиц. ДНК-гираза состоит из двух gyrА и двух gyrB субъединиц (соответствующие гены gyrА и gyrB). Топоизомераза IV - из субъединиц parC и parE (соответствующие гены parC и parE). Гены обоих ферментов локализованы на бактериальной хромосоме. МЕХАНИЗМЫ УСТОЙЧИВОСТИ К ФТОРХИНОЛОНАМ

Ступенчатое формирования устойчивости к фторхинолонам Устойчивость parC gyrA parC gyrA parC gyrA 1-я ступень селекции 2-я ступень селекции CiproR LevoR

ПУТИ ПЕРЕМЕЩЕНИЯ ГЕНЕТИЧЕСКОЙ ИНФОРМАЦИИ A. Трансформация B. Трансдукция C. Конъюгация (Рекомбинация)

A. Трансформация перемещение «голой» ДНК

B. Трансдукция Перемещение генетической информации бактериофагом

C. Конъюгация (Рекомбинация) Генетический материал перемещается непосредственно от одной клетки к другой через через эндоплазматический мост.



92 МАКРОЛИДЫ ФТОРХИНОЛОНЫ β-лактамы

THE END
12894-16_01_03_test_15_04_2010.ppt
- Количество слайдов: 93

